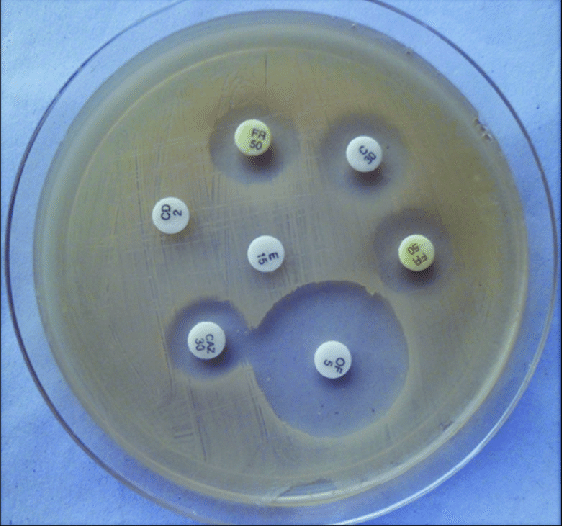

Trusted Partner for Medical and Healthcare Consumables
Trusted Medical Partner
Our Categories
Advanced Cartridge Design for Reliability and Stability
Modern antimicrobial susceptibility test disc cartridges are designed as spring-loaded canisters for easy and consistent dispensing of discs. Each cartridge is tightly sealed with desiccants to maintain very low humidity (below 2%), ensuring long-term stability and reliability of the antibiotic-impregnated discs during storage and use.
Cartridge of Antimicrobial Susceptibility Test Discs
Antimicrobial Susceptibility Test Disc Cartridges are essential tools in microbiology laboratories, designed to determine the effectiveness of antibiotics against bacterial pathogens.
Each cartridge contains a set of discs impregnated with precise concentrations of various antibiotics, used in both automated and manual systems to assess microbial resistance profile
New Collection
Available Types:
Cartridges compatible with automated testing systems (e.g., BD Phoenix, Bio-Rad, Thermo Scientific).
Standard manual cartridges for disk diffusion testing.
Multi-antibiotic cartridges designed for specific bacterial strains such as Staphylococcus aureus, E. coli, and Pseudomonas aeruginosa.
Rapid test cartridges for portable or field applications.